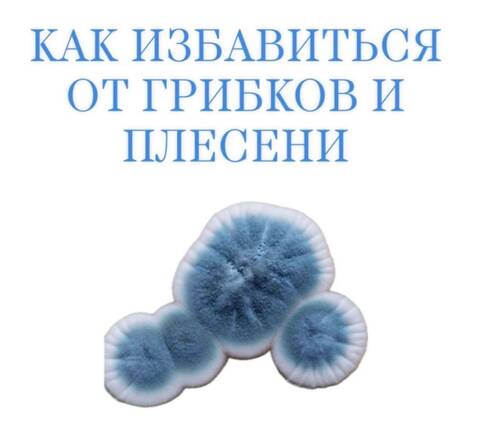
Самодиагностика Самодиагностика

КАК ИЗБАВИТЬСЯ ОТ ГРИБКОВ И ПЛЕСЕНИ В ОРГАНИЗМЕ ЧЕЛОВЕКА
Вытравить грибы из организма человека очень сложно. Если грибок уже заселился, и, условно говоря, развил свою грибницу, то возникают достаточно сложные проблемы.
Грибы бывают разные. Бывают, якобы благородные грибы, бывают низшие грибы (называются плесень). У грибов очень много названий, более 50 видов.
В чем заключается смысл гриба?
Смысл заключается в том, что у него есть генетический код и это не единичная особь, а особь, которая живет колониями. Между этими колониями существует точная взаимосвязь сегментов. То есть каждый грибной элемент связан с другими грибными элементами тысячами сегментных связей.
Если мы хотим, чтобы наш организм был свободен от грибов, единственное, что мы можем, это не давать ему пищу.
Если в нашем организме достаточно пищи для грибов, то они в нем будут.
Например, в хлебнице лежит хлеб. На нем образовалась плесень. Если вы хлеб уберете и оставите плесень, то постепенно эта плесень погибнет. Потому что ей нечего будет кушать. Она высохнет, не размножится, потому что для размножения ей нужны питательные вещества. Питается плесень в основном белковыми продуктами, потому что ей нужны аминокислоты.
Например, мы берем муку, в муку мы добавляем сахар, масло – энергию, добавляем воду, добавляем дрожжи (это и есть плесень особо рода – хлебная плесень). Дальше мы ей даем температуру, обязательно 37, дальше даем ей особую влажность и кислород. И тогда она начинает размножаться, реанимироваться. При чем до этого она лежала в холодильнике при температуре -18 .Или лежала в сухом виде еще 10 лет. У нее всхожесть немного уменьшится, но незначительно, она все равно взойдет. Убить плесень, даже если вы пережарите хлеб, невозможно. Потому что, если вы бросите сухари пережаренные в квас, квас будет бурлить. Это говорит о том, что как только она попадет в белково – углеводную среду, то начинает размножаться.
Всё, что является дрожжевым, для нас несет определенную плесневелую опасность.
Потому что виды плесени, они все содружественны, то есть это свой класс. Там, где живет одна плесень. Может жить другая, третья. Одна из самых патогенных плесеней для нас – это кандида.
Плесень – это слово объединяющее. На самом деле каждый грибок грибку рознь.
Ногтевые грибки – это не то же самое, что кандида.
Какие-то грибки поражают лимфатические узлы в паху, другие под грудью, третьи поражают ногтевую пластину и живут только на ногтях. Другие поражают только слизистые оболочки и живут во рту, в виде кандидозов и стоматитов или во влагалище в виде кандидозов и вагинитов. Какие- то грибки поражают кожные покровы и живут на коже в виде трещин, псориаза, экземы, нейродермита, но везде это класс грибы.
Как попадают грибы в организм:
С испорченной пищей.
С водой.
С воздуха.
Со старыми пыльными вещами.
Если фрукт или овощ с плесенью, то их есть нельзя. Если в ящике есть плесень, то она есть на всех фруктах.
В нашем организме есть хороший фактор – это концентрация желудочного сока, который эту плесень подавляет, и по идее через желудочно–кишечный тракт не должны проникать.
Плесень может проникать через кожу. Везде, где мы паримся, где мы ходим босиком, везде, где для плесени есть условия, то есть влажность, температура, органические остатки (например, грязь или жир человеческий) – для нее есть еда.
Как проникает грибок между пальцами ног? Он через неповрежденную кожу не просочится. Но если в коже есть микротравмочки: царапинки, опрелости, повреждения кожного покрова, то грибок мгновенно туда цепляется. И стоит ему пройти кожный барьер, как он приживается.
ПРИЗНАКИ ГРИБА в организме человека:
Всё, что зудит. Вот говорят: «У меня собака заболела» «Что с собакой?» «Ухо простудила» «Что делает?» «Чешет». Если собака чешет ухо, значит, у нее в ухе грибок. Если человек чешет ухо спичкой, зубочисткой, то здесь один вариант – грибок, других вариантов нет. Что-то у меня в ухе случилось, что-то там болит, что-то там течет, но если появился зуд – это грибок.
Трещины, пузыри, потертости (не мозоли, а образуются потертости, непонятного характера, вроде бы ничего не стирали, например, в паховых складках – образуется что-то мокнущее).
Везде, где шелушится, трескается и мокнет одновременно. Всё, что на руках, под мышками, в паховых складках – это все грибы. Если откуда – то выделяется что-то белое, творожистое – то это тоже грибы. Неважно, изо рта ли, влагалища, или бронхов, миндалин. Всё, что на языке белое, творожистое, крупинчатое – это все грибы.
Вечером спать легли – язык был нормальный, утром встали – обложен белым налетом. Белый налет- это и есть грибок. Лимфатическая система всю ночь собирает этот белый налет на ворсиночках языка, как на ковриках у двери, откладывает, потому что дальше он идет на выброс. Слущивается с языка и вместе с питанием выплевывается, либо отхаркивается. Надо язык отскабливать палочкой, либо ложечкой. Налета на языке быть не должно. Язык должен быть розовым, с выраженными сосочками.
Всё, что не болит – это грибок. Потому что грибы перегрызают нервные окончания. К коже идёт огромное количество нервных окончаний. Что бы чувствовал больной псориазом, если огромные поверхности его кожи постоянно, ежесекундно бы раздражались, он бы просто с ума сошел от боли. Когда мы кнопкой уколем палец, боль такая, что мы подскакиваем. Если бы поверхности псориаза были бы болезненны, то это было бы сильное болевое раздражение, и человек бы умер от болевого шока. Грибок целенаправленно с этим работает, он все откусывает, завоевывает кожу и делает ее управляемой. У него там свои замки, свои дворцы.
Всё, что на коже обсыпается, отпадает, возвышается, шелушится кольцами (равномерно, неравномерно), везде, где есть чешуйки. Как правило, грибок располагается в зоне крупных лимфатических узлов, по одной простой причине – грибок находится в межклеточном пространстве. Вот клетка, вот межклеточное пространство – вода, потенциал этой воды – 50 приблизительно. Среда должна быть либо щелочная, либо кислая, вокруг клеток размножается грибок. Сюда он попадает с током крови с пищеварительного тракта в межклеточную воду. Межклеточная вода должна протекать, каждое утро сюда должна поступать вода и каждое утро она должна стравливаться и уходить. Стравливается она через лимфатическую систему. Лимфатические протоки заканчиваются лимфатическими узлами. В лимфатических узлах отсеки, 10 входов, один выход. И здесь происходит обработка лимфоцитами тех жизненных молекулярных форм, которые засосались сюда и происходит очищение. Чистая лимфа идет в одну сторону, а грязная лимфа идет в другую, на выброс.
У человека заболел коленный сустав. Что тут может болеть? Кости болеть не могут, хрящ тоже, там нет болевых окончаний. Между хрящами находится жидкость. Она тоже не болит, но она может быть воспалена, в ней может кто – то жить. Сзади за суставом, со стороны подколенной ямки, есть лимфоузлы. Если есть грибок на ногах, он будет подниматься вверх, к подколенным лимфоузлам. Лимфоузлы грибок задержат, и в этот момент они перестанут пропускать воду наверх. Сустав опухнет. А когда он будет опухать, он заболит.
Что сделает организм? Он поднимет температуру, чтобы усилить микроциркуляцию, чтобы в сустав пришли лейкоциты.
Что сделает врач? Обезболит, назначит аспирин.
Сначала нужно разобраться, что тут в суставе. Либо грибы, либо бактерии.
Если у человека все ногти на ногах в грибках, что у него в суставе? Грибы. И никакие антибиотики здесь не помогут. Потому что лимфатическая система верхнего сегмента будет держать то же самое, что находится в нижнем сегменте, чтобы они не прошли дальше, иначе грибок завоюет все. Это кордон, это пограничная застава. Выше её никто не пройдет. Если где- то кто – то поселился, то там развивается война. Война между лейкоцитами и тем, кто поселился. Тот, кто поселился, бывает 5 видов. Вирусы, грибы, гельминты, простейшие, бактерии (посмореть программу против паразитов). Простейшие в суставах не живут. Тут не живут токсоплазмы, лямблии, описторхи. Если в суставе кто – то поселился, заболевание будет оканчиваться на – ит. Бронхит, артрит, гайморит, гастрит, синусит, конъюктивит, стоматит, нефрит и так далее. Кто- то там живет, там идет война, инфекция.
Инфекция бывает 5 видов.
Чтобы было понятно, гайморит, это у нас как? Какой–то гной в носу. Что за гной в носу, откуда он там взялся? Нос – это дырка, просто дырка, и просто пазуха. Больше ничего нет, там никакого гноя быть не может. Он может подойти на эскалаторе лимфатической системы. Но подойдет он по своему пути. Почему он в нос идет? На выброс, выход наружу. Может пойти в бронхи, во влагалище, в кишечник. С верхней части тела идет в нос, из половых путей в нос не пойдет. С половых путей он высадится на первом этаже лифта. Бесполезно бороться с белями и выделениями, с этим бороться не надо. Если они есть, это говорит о чем? Что есть грибок и что работает лимфатическая система. Когда вы его не трогали, а он сам по себе прошел, о чем это говорит? Что все нормально, что все справилось, если он самостоятельно прекратился. Вот вы пьете все в желудок, а что вы, например, пьете такого? Чеснок, или берете перец горький и 20 штук съели сразу, прямо горошины. И у вас остановится сразу весь понос.
Если вы (теоретически) пьете противогрибковые препараты или продукты, или травы, или эфирные масла, то все, что говорили о продукте, то же касается и эфирного масла этого продукта.
Грейпфрут, чайное дерево – все действует точно так же, как и сам продукт. Растение может у нас быть нескольких видов. Само растение, отвар растения, напар растения, эфирное масло растения, масло растения, листья растения, лапки растения, настойка растения. Любая продукция, приготовленная из растения, будет действовать так же, как и само растение. Возьмете вы петрушку или сок из петрушки, сок из клюквы или саму клюкву, без разницы, все работает одинаково.
Вот вы взяли масло кунжута, а кунжут сам по себе является сильным противопаразитарным средством. Масло кунжута вы добавляете в салат, оно очень вкусное, попробуйте черное масло кунжута, так плюс к этому оно является очень мощным антипаразитарным средством. Вы просто кушаете салат, помидоры, огурцы, петрушка, тмин, укроп, сельдерей и добавляете масло кунжута, семена кунжута и у вас получается очень вкусный, противопаразитарный салат.
Если у вас каждый день что–то такое противопаразитарное, противогрибковое будет поступать, то у вас не будет ни вирусов, ни бактерий, ни паразитов, ничего не будет. Только в допустимых нормах, либо в минимальных концентрациях, что вам не принесет никакого вреда. Посмотрим вокруг себя, внутрь себя. Наша центральная нервная система настолько мощна, что может любой иммунитет послать в любое место, раскопать любую войну и прекратить ее.
Но для этого нужно что? Энергия, целеустремленность, для этого нужны знания, нужна большая вера, для этого нужен правильный образ жизни, алгоритм, который нужно будет делать каждый день.
Сказано, чеснок каждый день, значит чеснок каждый день. Не переносите чеснок, значит, хрен каждый день. Хрен не переносите, значит, редьку каждый день.
Найдите то, что вы переносите. 10 видов перца переносите, белый, красный, желтый, но это должно быть. Потому что грибок все завоюет, если вы даете ему каждый день макароны, на завтрак у него хлеб дрожжевой, на обед у него сгущенное молоко, на ужин у него картошка. Видели, как картошка плесенью покрывается? В три секунды. Попробуйте редиску плесенью покрыть. Замучаетесь. Бывает иногда, когда в воздухе много спор или сметана рядом стояла.
Вы видели когда нибудь, чтоб растительное масло плесневело? Не сильно. Прогоркает, но плесневеет несильно. Потому что там грибкам делать нечего, там есть особые вещества. Растения, которые находятся в противоборстве с грибками. Они ненавидят гельминтов, почти все, у них есть разум и они находятся в противоборстве с гельминтами, вирусами, бактериями и со всеми остальными. Они за нас. За себя и за нас. Они выискивают средства, каждое растение выискивает что – то такое, чтобы его не съели. Кто не съел? Грибы, вирусы, бактерии, паразиты и мы. Потому что мы тоже не всегда все правильно делаем, против нас тоже кое – что настроено, мы не можем все съесть, нам нельзя все съесть.
Но вот если мы знаем, что растение уже настроилось, мы это растение можем использовать в свое благо. Это очень важно, понимать, что делают грибы в организме. Просто живут. Они питаются, размножаются, двигаются, перемещаются. А мы их что делаем? Кормим, выращиваем, и постоянно добавляем, каждый Божий день. То мы пьем кефирный грибок, то мы пьем сопливый чайный гриб, то мы пьем кордецепс, то пиво пьем, то с утра до ночи едим дрожжевой хлеб, то еще дрожжи пить начинаем.
ПРОТИВОГРИБКОВЫЕ ПРОДУКТЫ.
ЧЕСНОК, ЛУК. Все, что является противопаразитарным, одновременно является и противогрибковым, но добавляется другое еще.
Хвоя, пихта, сосна, ель. Вся ЖИВИЦА сюда добавляется. Живица, это то, что течет, смола от ели, чтоб ее не съел грибок. Сосна законсервирована, то есть она не боится грибка, она живет не 30 лет, как береза. И поэтому кедр долго живет, вся хвойная порода. Ее можно класть в компоты, делать отвары, напар, можно настаивать на воде, можно кипятить и вдыхать пар. Лучше всего молодые лапки хвои сосны, пихты иметь засушенные, просто класть в чай, можно готовить любые напитки. Смолу можно жевать, добавлять в жвачку. Все, что обладает противогрибковым действием, обладает этим действием в маслах.
Масло кедрового ореха тоже противогрибковое.
Чайное дерево и все продукты из чайного дерева.
Если идет тяжелая грибковая патология, то можно по одной капле масла чайного дерева разводить в 1 чайной ложке жира и съедать, потому что в воде оно не растворяется. Если это делать подряд 2 месяца, то с грибком можно будет серьезно посоперничать.
Прополис. Можно пить настойку прополиса или водный отвар, или напар, класть прополис в мед, просто его жевать, кушать соты. Можно кусок прополиса просто за щеку засунуть, пусть он там лежит и всасывается в слюну.
Перец, редька, хрен, приправы (зира, куркума и др.).Все то, что является антигельминтным, одновременно является и противогрибковым.
Смородина, крыжовник, калина, рябина, брусника, клюква, облепиха, черника, ежевика, голубика – все кислые ягоды, они являются противогрибковыми.
По материалам Ольги Бутаковой
«Грибы: необъявленная война»